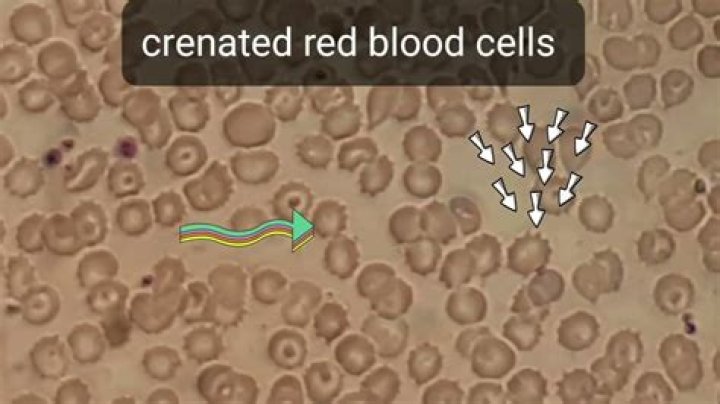
Do blood cells crenate?

Do blood cells crenate?
Score: 4.4/5 (45 votes) When red blood cells are in a hypertonic (higher concentration) solution, water flows out of the cell faster than it comes in. Th...
Score: 4.4/5 (45 votes) When red blood cells are in a hypertonic (higher concentration) solution, water flows out of the cell faster than it comes in. Th...

Score: 4.8/5 (37 votes) We don't have any children and I've never wanted family life. I've probably inherited a feeling of being trapped i...

Score: 4.6/5 (49 votes) It's been 98 years since the Equal Rights Amendment—which would expressly forbid any sort of discrimination on the basis of ...

Score: 5/5 (4 votes) This is a myth that many people believe, but it is not true! Once the sperm is DRY it is dead and cannot travel to fertilize an egg....

Score: 4.7/5 (66 votes) Heliod blames Elspeth for Xenagos's ascension, and she is forced to flee into the wilderness to escape his wrath. Instead of...

Score: 4.6/5 (30 votes) The purpose of the laboratory remount is to correct errors in occlusion that have occurred during processing, to return the dentu...

Score: 4.9/5 (15 votes) Lalique items such as vases, bowls and even perfume bottles were converted to lamps after they left the factory. ... Certain vase...

Score: 4.2/5 (67 votes) Potential Health Benefits of Marmite Marmite is full of vitamin B12. Research has linked vitamin B12 deficiency. Is Marmite high ...

Score: 4.1/5 (46 votes) Transaction sentence example. The council meets once a week for the transaction of the business of government. Such a transaction...

Score: 4.4/5 (38 votes) noun Botany. increased growth along the lower surface of a plant or plant part, causing it to bend upward. What is Hyponasty move...

Score: 4.5/5 (45 votes) ha(i)-dee. Origin:Greek. Popularity:28559. Meaning:well-behaved or modest. Where does the name Haidee come from? The name Haidee ...

Score: 4.4/5 (47 votes) (In the late 18th century, some Western nations resisted performing the ritual, which acknowledged the Chinese emperor as the "so...

Score: 4.8/5 (24 votes) The most common symptom of a stomach ulcer is a burning or gnawing pain in the centre of the tummy (abdomen). But stomach ulcers ...